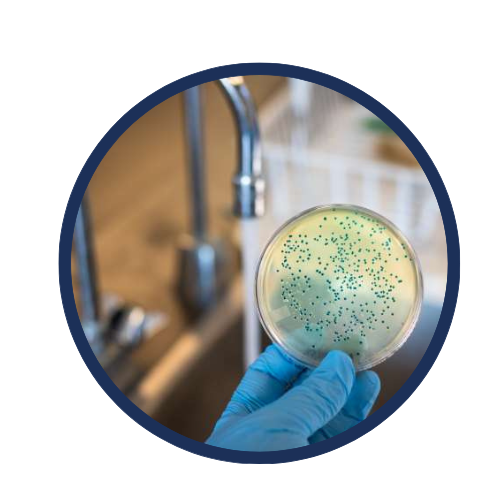

Вашата Защита от Замърсяването
✅По-добро хидратиране
✅Бистра и Безопасна вода
✅По-добро здраве на кожата
✅Премахва 100+ замърсителя
✅5-степпени нива на филтрация
С всяка система получавате един БЕЗПЛАТЕН филтър, който общо издържа до 60 до 90 дни – в зависимост от това колко често използвате системата и колко замърсени са тръбите ви.

Подарък - 5 Адаптера пригодени за всяка мивка
При закупуване на филтрираща система получавате 5 БЕЗПЛАТНИ универсални адаптера – от малки до големи размери, които позволяват системата да бъде инсталирана на всяка мивка.
Монтиране за под 2 минути
Защо филтриращата система на PurVoda

|

|
|
|---|---|---|
| Нова иновативна технология | ||
| Мигновенно филтриране | ||
| Бавно филтриране | ||
| Възможност за гореща вода | ||
| компактност |
14 Дeна Право на Тест
Ние вярваме в качеството на нашата филтрираща система и искаме да ти предложим покупка БЕЗ РИСК. Ако по някаква причина не си напълно доволен/а, можеш да върнеш продукта в рамките на 14 дни!
Контакти за връщане:
✉️ support@purvoda.bg
📞 087 643 5566
Често задавани въпроси
Могат ли да се закупят допълнителни филтри?
Могат ли да се закупят допълнителни филтри?
Да, разбирасе. Можете да закупите допълнително филтри тук от сайта ни или като се свържите с нас по телефон: 0876435566
Подходящ ли е филтърът за всички видове кранове?
Подходящ ли е филтърът за всички видове кранове?
Филтърът е съвместим с повечето стандартни кранове. За нестандартни модели можете да използвате приложените адаптери. Ако имате въпроси за съвместимостта, свържете се с нас.
Purvoda НЕ пасва на кранове с квадратна форма, изтеглящи се, ръчни, със спрей или кранове със сензор.
С колко филтъра идва системата при покупка?
С колко филтъра идва системата при покупка?
Една система идва с един филтър.
Колко време издържа един филтър?
Колко време издържа един филтър?
Средната продължителност на един филтър е около 2–3 месеца (или до 300 литра пречистена вода), зависи от честотата на използване и качеството на водата.
Ако се нуждаете от нов или допълнителен филтър, имате възможност да поръчате допълнително от сайт ни.
Колко време отнема да получите продукта си?
Колко време отнема да получите продукта си?
В рамктите на 1 до 3 работни дни, в зависимост дали е работен ден или не. 90% от пратките са получени още на следващия ден с Екон и Спиди до офис или адрес.
Лесно ли се инсталира филтриращата систеама?
Лесно ли се инсталира филтриращата систеама?
Да, инсталацията е бърза и лесна, отнема само няколко минути. Включени са и необходимите адаптери.
Ще намали ли филтърът водното налягане?
Ще намали ли филтърът водното налягане?
Филтърът е проектиран така, че да минимизира загубата на налягане, като същевременно осигурява оптимално филтриране.
Какво премахва филтърът от водата?
Какво премахва филтърът от водата?
Филтърът премахва хлор, пестициди, тежки метали, бактерии, неприятен вкус и мирис, както и други замърсители, които могат да се съдържат в чешмяната вода.
Колко място ще заеме системата?
Колко място ще заеме системата?
Системата на PurVoda е изключително компактна – на дължина слиза надолу 4.5 сантиметра, а на широчина е 11 сантиметра.